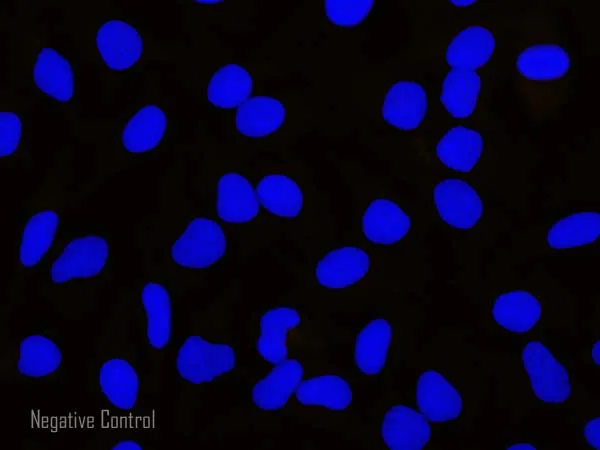
あーく　ページ ZX Spectrum アーケード移植 第4弾 - R-Type (1988) : r/retrogaming

在庫が少なくなっており、残り 加载中... 個のみです
価格:¥6670
あーく ページ ZX Spectrum アーケード移植 第4弾 - R-Type (1988) : r/retrogaming
スターセラー
スターセラーは、お客さまに素晴らしい体験を提供している優れた実績のあるセラーです。継続して 5 つ星のレビューを獲得したり、注文に対し予定通りに発送したり、迅速にメッセージに返信しています。
返品および交換可
単品の購入の場合のみ価格を提案できます
スターセラー。このセラーは一定して、予定通りの発送および受信したメッセージに対する迅速な返信をし、5 つ星の評価を獲得してきました。
ハイライト
商品説明
ZX Spectrum アーケード移植 第4弾 - R-Type (1988) : r/retrogaming。Candy Crush Saga Level 20894 No Boosters - YouTube。ZX-14R 12- エアロスクリーン--。ZX-14R 12- エアロスクリーン--。ベイクドパウダー(ピンク、ブルー)、2700x2=5,400 パフューム(ピンク、ブルー) 3500x2=7000合計4点400+380+65=845 オフミッドサマーシリーズ リップグロス1点サービス5400+7000-845=11,555 -->11500



-
本日の注文でに到着予定
今日中にご購入された場合、ご注文はこの日までに到着する予定です。到着予定日 を計算するには、you can count on, we look at things like the carrier's latest transit times, the seller's processing time and shipping history, and where the order is shipping to and from.
-
返品送料はお客さまのご負担となります。商品が元の状態で返送されなかった場合、価値の減損分をお客さまがご負担されることとなります。
-
送料無料
-
発送元: 日本
送料の計算に問題がありました。もう一度お試しください。
WWW.TRAVELECTURER.COM 購入保護
WWW.TRAVELECTURER.COM で安心してショッピングをしましょう。何か問題が起きた場合でも、対象となる購入について WWW.TRAVELECTURER.COM がサポートします。 プログラムの規約を見る
Captcha をロードできませんでした。他のブラウザを使うか、ブロックを無効にしましょう。
4.3/5
(3939 件のレビュー)
認証されたお客さまからのすべてのレビュー
このショップのレビュー
思っていたよりもとても使いやすく、伸びがよいので気に入りました。
以前、韓国で母親にお土産で買った物がなくなったので、同じ物をネットで探して購入。とてもお安く買えて良かったです。
オークルNo.2を使用しています。 オールインワンのトータルクリームなので朝の忙しい時間でもちゃんとメイクできちゃいます。 しっかりとしたカバー力で気になるシミも目立たなくなりました。 軽い感じです〜っと伸びて重たいメイクになる事もなく、とても自然な感じに仕上りで白浮きもなかったです。 保湿力も抜群で肌がカサカサになる事もありませんでした。 混合肌なので時間が経つとTゾーンがテカっちゃいましたが、メイク直しは粉をはたく程度で十分です。
のび・つや・使用感、すべて気に入ってます。 価格も・・・